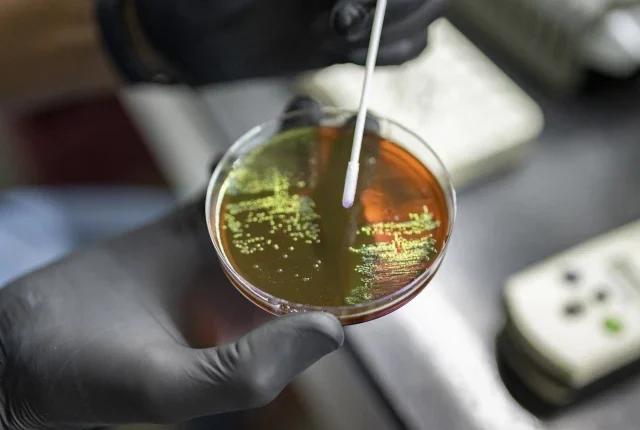

جنیوا:
عالمی ادارہ صحت کی تنظیم نے جمعرات کو متنبہ کیا ہے کہ پائپ لائن میں پائپ لائن میں کافی نئے ٹیسٹ اور علاج موجود نہیں ہیں۔
ڈبلیو ایچ او کا کہنا ہے کہ اینٹی مائکروبیل مزاحمت (اے ایم آر) کی بڑھتی ہوئی پھیلاؤ – خاص طور پر اینٹی بائیوٹکس کے لئے نقصان دہ بیکٹیریا کی بڑھتی ہوئی مزاحمت – عوامی صحت کے عالمی عالمی خطرات میں سے ایک ہے ، اور سوچا جاتا ہے کہ سالانہ ایک ملین سے زیادہ اموات کا سبب بنتا ہے۔
اقوام متحدہ کی صحت کی ایجنسی کا کہنا ہے کہ انسداد بائیوٹکس ، اینٹی ویرلز اور اینٹی فنگلز سمیت انسداد مائکروبیلس کے غلط استعمال اور زیادہ استعمال سے انسانوں ، جانوروں اور پودوں میں منشیات کی مزاحمت کا سب سے بڑا ڈرائیور ہے ، امر کو کم اور درمیانی آمدنی والے ممالک میں غیر متناسب بوجھ پڑتا ہے۔
بیکٹیریل انفیکشن کے نئے ٹیسٹ اور علاج کے بارے میں جڑواں رپورٹوں میں ، ڈبلیو ایچ او نے متنبہ کیا کہ بہت کم تر ترقی ہے۔
"اینٹی مائکروبیل مزاحمت بڑھ رہی ہے ، لیکن نئے علاج اور تشخیص کی پائپ لائن منشیات سے بچنے والے بیکٹیریل انفیکشن کے پھیلاؤ سے نمٹنے کے لئے ناکافی ہے۔”
"تحقیق اور ترقی میں زیادہ سرمایہ کاری کے بغیر ، اس بات کو یقینی بنانے کے لئے سرشار کوششوں کے ساتھ کہ نئی اور موجودہ مصنوعات ان لوگوں تک پہنچیں جن کی زیادہ تر ضرورت ہوتی ہے ، منشیات سے بچنے والے انفیکشن پھیلتے رہیں گے۔”
اے ایم آر کی تعریف ڈبلیو ایچ او کے ذریعہ کی جاتی ہے جب مائکروجنزم جیسے بیکٹیریا ، وائرس اور پرجیویوں کو اب اینٹی مائکروبیل دوائیوں کا جواب نہیں ملتا ہے۔
‘دوہری بحران’
ڈبلیو ایچ او نے 2017 میں اینٹی بیکٹیریل ایجنٹوں کی ترقی کا سراغ لگانا شروع کیا۔
تب سے ، ترجیحی بیکٹیریل پیتھوجینز کے خلاف 17 نئے اینٹی بیکٹیریل ایجنٹوں نے مارکیٹ کی اجازت حاصل کی ہے۔ 2023 میں اس کی آخری تازہ کاری میں ، کلینیکل پائپ لائن میں 97 اینٹی بیکٹیریلز تھے – جن کا انسانوں پر تجربہ کیا جارہا ہے۔
یہ تعداد اب 90 پر آگئی ہے ، جو انتباہ ہے۔